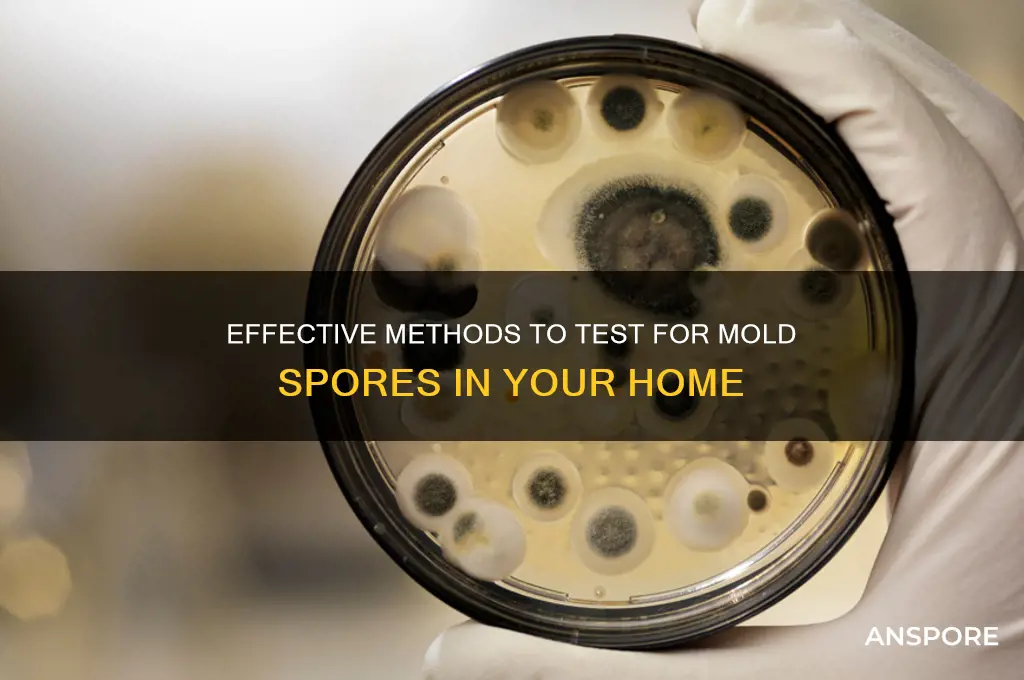
how do you test for mold spores

Testing for mold spores is a critical step in identifying and addressing potential mold issues in indoor environments. Mold spores are microscopic particles that can become airborne and settle on surfaces, often thriving in damp, humid conditions. To detect their presence, various methods are employed, including air sampling, surface testing, and bulk sampling. Air sampling involves collecting air from a specific area and analyzing it for spore concentration, while surface testing uses swabs or tape lifts to gather samples from visible mold or suspected areas. Bulk sampling, on the other hand, involves removing material from a contaminated area for laboratory analysis. Professional mold testing kits and services often utilize these techniques to provide accurate results, helping homeowners and businesses take appropriate remediation measures to ensure a healthy living or working environment.
| Characteristics | Values |
|---|---|
| Testing Methods | Air Sampling, Surface Sampling, Bulk Sampling, ERMI (Environmental Relative Moldiness Index) |
| Tools Required | Air pumps, spore traps, swabs, tape lifts, moisture meters, mold test kits |
| Sample Collection | Collect air or surface samples from suspected mold areas |
| Laboratory Analysis | Samples are sent to a lab for microscopic or DNA-based analysis (e.g., PCR) |
| DIY Test Kits | Available for home use, but may lack accuracy compared to professional testing |
| Cost | DIY kits: $10–$50; Professional testing: $300–$800+ depending on scope |
| Turnaround Time | DIY: Immediate results; Lab testing: 2–7 days |
| Accuracy | Professional lab testing is more reliable than DIY kits |
| Detection Limit | Can detect spores as low as 1–10 spores/m³ depending on the method |
| Common Mold Types Detected | Aspergillus, Penicillium, Stachybotrys (black mold), Cladosporium |
| Health Implications | Identifies potential allergens, toxins, or irritants from mold exposure |
| Regulatory Standards | Follows guidelines from EPA, OSHA, or local health departments |
| Precautions | Wear PPE (gloves, masks) during sampling to avoid exposure |
| Applications | Residential, commercial, industrial, and healthcare settings |
| Reporting | Detailed reports with spore counts, types, and recommendations |
Explore related products
What You'll Learn
- Air Sampling Techniques: Use spore traps, impactors, or pumps to collect airborne mold spores for analysis
- Surface Testing Methods: Swab, tape lift, or bulk sample surfaces to detect mold growth directly
- Laboratory Analysis: Identify spore types and concentrations via microscopy or DNA-based testing
- DIY Mold Test Kits: Use at-home kits for preliminary detection, but confirm results with professionals
- Moisture Meter Use: Measure moisture levels to identify areas prone to mold spore growth

Air Sampling Techniques: Use spore traps, impactors, or pumps to collect airborne mold spores for analysis
Airborne mold spores are invisible threats that can compromise indoor air quality and health. To detect their presence, air sampling techniques employing spore traps, impactors, or pumps are essential tools. Each method captures spores from the air, allowing for laboratory analysis to identify types and concentrations. This data helps assess mold severity and guides remediation efforts, ensuring a healthier environment.
Spore traps, the most common air sampling tool, operate by drawing air through a sticky surface or adhesive slide. As air passes, mold spores adhere to the surface, where they can later be examined under a microscope. This method is cost-effective and straightforward, making it ideal for initial mold assessments. However, it may not differentiate between viable and non-viable spores, limiting its diagnostic precision. For best results, place the spore trap in areas with suspected mold growth, such as near water damage or in damp basements, and run it for 5 to 15 minutes, depending on the manufacturer’s guidelines.
Impactors, in contrast, use a more forceful approach by accelerating air onto a collection surface, where larger spores are captured. This technique is particularly effective for identifying specific spore types due to its ability to separate particles by size. However, impactors can be more expensive and require careful handling to avoid contamination. They are best suited for detailed analyses where spore size distribution is critical. When using an impactor, ensure the airflow rate is calibrated to industry standards, typically between 28.3 and 30 liters per minute, to achieve accurate results.
Pumps, often paired with spore traps or impactors, provide the necessary airflow to collect samples efficiently. These devices can be calibrated to specific volumes, ensuring consistent and reliable data. For instance, a pump set to 15 liters per minute for 10 minutes will collect a known volume of air, aiding in precise spore concentration calculations. When using pumps, place them in central locations or areas of concern, and ensure the sampling duration aligns with the size of the space. For example, larger rooms may require longer sampling times to capture representative data.
Choosing the right air sampling technique depends on the investigation’s goals. Spore traps offer simplicity and affordability, while impactors provide detailed spore size analysis. Pumps enhance both methods by ensuring controlled airflow. Regardless of the tool, proper placement and adherence to guidelines are critical for accurate results. Always consult a professional or follow manufacturer instructions to avoid errors that could compromise the analysis. By mastering these techniques, you can effectively detect and address airborne mold spores, safeguarding indoor environments.
Growing Mushrooms Without Spores: Alternative Methods Explored
You may want to see also

Surface Testing Methods: Swab, tape lift, or bulk sample surfaces to detect mold growth directly
Mold testing on surfaces is a critical step in identifying hidden infestations before they escalate. Among the most direct methods are swab, tape lift, and bulk sampling, each offering unique advantages depending on the surface type and suspected contamination level. Swab tests, for instance, involve using a sterile swab moistened with a solution (often distilled water or phosphate buffer) to collect mold from a defined area. This method is ideal for smooth, non-porous surfaces like glass or tile, where spores can be easily dislodged. The swab is then sent to a lab for analysis, typically via microscopy or culture, to determine mold presence and species.
Tape lifts, on the other hand, are particularly effective for textured or porous materials like concrete or wood. A piece of clear adhesive tape is pressed firmly onto the surface, lifting spores and hyphae fragments for examination. This method is quick and minimally invasive, making it suitable for preliminary assessments. However, it may not capture deeply embedded mold, limiting its effectiveness in severe cases. Labs often analyze tape lift samples under a microscope, providing rapid results but less quantitative data compared to swab tests.
Bulk sampling involves physically removing a portion of the material, such as a piece of drywall or carpet, for testing. This method is destructive but highly effective for confirming mold growth within porous materials. The sample is weighed, and a portion is sent to the lab for spore count analysis or DNA-based testing. Bulk sampling is particularly useful in legal or insurance cases, where tangible evidence of mold contamination is required. However, it’s labor-intensive and may not be practical for widespread testing.
Choosing the right method depends on the context. For example, swab tests are ideal for routine inspections in healthcare facilities, where cleanliness is critical. Tape lifts are better suited for quick assessments in residential settings, such as after water damage. Bulk sampling is reserved for situations where surface-level testing is inconclusive or when material replacement is already planned. Regardless of the method, proper sampling technique is essential—ensure the area is undisturbed before testing, and follow lab instructions for sample submission to avoid contamination.
In practice, combining these methods can provide a comprehensive picture of mold presence. For instance, a tape lift might reveal surface spores, while a swab test confirms active growth, and bulk sampling identifies hidden colonies. Each method has its limitations, but when used strategically, they offer a powerful toolkit for detecting mold before it becomes a health hazard or structural issue. Always consult a certified professional for accurate interpretation of results and remediation guidance.
Can Spores Survive in PRVs? Uncovering the Hidden Risks
You may want to see also

Laboratory Analysis: Identify spore types and concentrations via microscopy or DNA-based testing
Mold spores are invisible to the naked eye, yet their presence can significantly impact indoor air quality and human health. Laboratory analysis offers a precise method to identify spore types and quantify their concentrations, providing actionable data for remediation efforts. Microscopy, a traditional yet effective technique, involves examining spore morphology under a microscope. Technicians compare observed structures—such as size, shape, and color—to reference guides or databases to determine the species. For instance, *Stachybotrys chartarum*, often called "black mold," is identified by its dark, slimy appearance and distinctive spore chains. While microscopy is cost-effective and provides quick results, it relies heavily on the technician’s expertise and can struggle with fragmented or degraded spores.
In contrast, DNA-based testing, such as polymerase chain reaction (PCR) or next-generation sequencing (NGS), offers a molecular approach to spore identification. These methods detect specific genetic markers unique to each mold species, ensuring higher accuracy and sensitivity. PCR amplifies targeted DNA sequences, allowing for the detection of even low spore concentrations, often down to 1–10 spores per cubic meter of air. NGS, on the other hand, provides a comprehensive profile of all mold species present in a sample, making it ideal for complex environments like water-damaged buildings. While DNA-based testing is more expensive and time-consuming, it eliminates ambiguity and is particularly useful when dealing with mixed mold populations or unidentified species.
Both microscopy and DNA-based methods require careful sample collection to ensure accurate results. Air samples are typically collected using spore traps or impactors, which capture spores on a slide or cassette. Surface samples can be obtained via swabs, tape lifts, or bulk material collection. For instance, a tape lift involves pressing clear adhesive tape onto a surface to collect spores, which is then transferred to a slide for analysis. Regardless of the method, samples must be handled and stored properly to prevent contamination or degradation. Laboratories often provide specific guidelines, such as keeping samples refrigerated and submitting them within 24–48 hours of collection.
Choosing between microscopy and DNA-based testing depends on the specific needs of the investigation. Microscopy is ideal for quick, cost-effective assessments where preliminary identification suffices. For example, a homeowner suspecting mold after a minor leak might opt for microscopy to confirm the presence of common species like *Aspergillus* or *Penicillium*. DNA-based testing, however, is recommended for high-stakes situations, such as post-flood assessments or cases involving immunocompromised individuals, where precise identification and quantification are critical. Combining both methods can provide a comprehensive understanding of mold contamination, leveraging the strengths of each technique.
In conclusion, laboratory analysis of mold spores through microscopy or DNA-based testing is a cornerstone of accurate mold assessment. While microscopy offers speed and affordability, DNA-based methods provide unparalleled precision and depth. Proper sample collection and handling are essential for both approaches, ensuring reliable results. By understanding the strengths and limitations of each technique, professionals can tailor their testing strategies to address specific mold concerns effectively, safeguarding both property and health.
Windblown Spores, Swimming Sperm, and Megaphylls: Evolution's Marvels
You may want to see also
Explore related products

DIY Mold Test Kits: Use at-home kits for preliminary detection, but confirm results with professionals
Mold spores are invisible to the naked eye, yet their presence can significantly impact indoor air quality and health. DIY mold test kits offer a convenient first step for homeowners to detect potential mold issues. These kits typically include petri dishes, swabs, or air sampling cassettes, along with instructions for collecting samples from surfaces or air. For instance, a surface test might involve swabbing a suspicious area, while an air test requires leaving a cassette open for a specified time, often 5–10 minutes, to capture airborne spores. Results usually appear within 48–72 hours as visible mold growth in the petri dish or on the swab. While these kits are user-friendly and affordable, ranging from $10 to $50, they are not definitive. False positives or negatives can occur due to improper sampling techniques or misinterpretation of results. Thus, they serve best as a preliminary tool to identify potential problem areas rather than a conclusive diagnosis.
Analyzing the limitations of DIY mold test kits reveals why professional confirmation is essential. These kits often lack the precision of laboratory testing, which can identify specific mold species and their concentrations. For example, while a DIY kit might indicate the presence of mold, it cannot distinguish between harmless varieties and toxic strains like *Stachybotrys chartarum* (black mold). Additionally, DIY tests may not account for environmental factors, such as humidity levels or hidden mold behind walls, which professionals can detect using advanced tools like moisture meters or thermal imaging cameras. Misinterpreting DIY results can lead to unnecessary panic or, worse, ignoring a serious problem. Therefore, while these kits are useful for initial screening, they should always be followed up with a professional inspection to ensure accuracy and appropriate remediation.
Persuasively, the value of DIY mold test kits lies in their accessibility and proactive nature. For renters or homeowners on a budget, these kits provide an affordable way to monitor indoor air quality and address concerns before they escalate. They are particularly useful in high-moisture areas like bathrooms, basements, or kitchens, where mold is likely to thrive. However, relying solely on DIY results can be risky. Professional mold inspectors bring expertise, specialized equipment, and the ability to provide actionable solutions, such as recommending ventilation improvements or identifying water leaks. Think of DIY kits as a thermometer for a fever—they signal a problem but don’t prescribe treatment. By combining the convenience of at-home testing with the thoroughness of professional assessment, homeowners can ensure a healthier living environment.
Comparatively, DIY mold test kits and professional inspections serve complementary roles in mold detection. While DIY kits are ideal for quick, surface-level assessments, professional services offer depth and certainty. For instance, a homeowner might use a DIY kit to test a musty-smelling closet, then call in experts if the results are positive. Professionals can then conduct more extensive testing, such as air quality analysis or wall cavity inspections, to determine the full extent of the issue. This two-step approach balances cost-effectiveness with reliability, ensuring that minor concerns don’t go unnoticed but also preventing overreaction to false alarms. Ultimately, DIY kits are a valuable starting point, but they should never replace the expertise of certified mold inspectors.
Milky Spore and Bee Safety: What Gardeners Need to Know
You may want to see also

Moisture Meter Use: Measure moisture levels to identify areas prone to mold spore growth
Mold thrives in damp environments, making moisture control the cornerstone of mold prevention. A moisture meter is an invaluable tool in this battle, allowing you to pinpoint areas within your home susceptible to mold growth before it becomes visible. These handheld devices measure the moisture content in various materials, such as drywall, wood, and concrete, providing a quantitative assessment of potential mold hotspots.
By identifying these areas early, you can take proactive measures to address the moisture source and prevent mold spores from taking hold.
Using a moisture meter is straightforward. Simply select the appropriate material setting (wood, drywall, etc.) and press the pins or flat surface against the material you want to test. The meter will display a percentage indicating the moisture content. Generally, readings above 16% moisture content are cause for concern, as they create an environment conducive to mold growth. For wood, ideal moisture levels typically range between 6% and 14%, depending on the type and intended use.
Refer to the meter's instructions for specific material guidelines and interpretation of readings.
While moisture meters are powerful tools, it's crucial to remember they measure moisture content at a specific point. Mold can grow behind walls, under floors, or in hidden cavities, so a single reading doesn't guarantee the absence of mold. Combine moisture meter readings with visual inspections, paying attention to areas prone to moisture accumulation like bathrooms, kitchens, basements, and around windows and pipes. Look for signs of water damage, discoloration, musty odors, or visible mold growth.
Investing in a moisture meter empowers you to take a proactive approach to mold prevention. By regularly monitoring moisture levels in vulnerable areas, you can identify potential problems early, address the source of moisture, and create an environment inhospitable to mold spores. Remember, preventing mold growth is far easier and less costly than dealing with a full-blown infestation.
Fungal Sexual Spores: Haploid or Diploid? Unraveling the Mystery
You may want to see also
Frequently asked questions
The most common methods include air sampling, surface sampling, and bulk sampling. Air sampling uses a pump to collect airborne spores, surface sampling involves swabbing or tape-lifting from surfaces, and bulk sampling collects material like drywall or carpet for testing.
DIY mold test kits are available, but they may not provide accurate or detailed results. For reliable testing, especially in cases of suspected mold infestation, hiring a certified mold inspector or industrial hygienist is recommended.
Costs vary depending on the method and extent of testing. DIY kits range from $10 to $50, while professional testing can cost between $300 and $800, depending on the size of the area and the number of samples taken.
Results typically take 2 to 5 business days for laboratory analysis. Rapid tests may provide results within 48 hours, but they are less accurate than lab-based methods.
Results indicate the types and concentrations of mold spores present. They help determine if mold levels are elevated compared to normal outdoor levels and identify specific species, which can guide remediation efforts.































